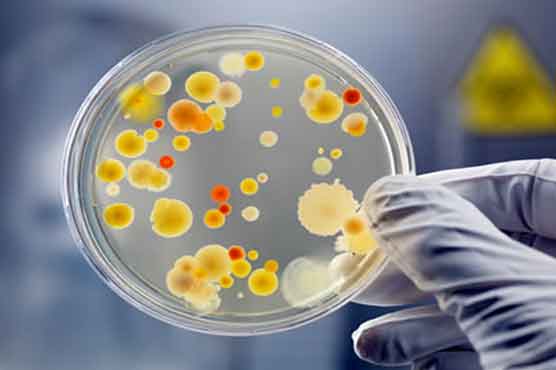
Global moot on microbiology from Dec 28 at KU

Summary Pakistan Society for Microbiology says its 9th conference would be held from Dec 28 to 31.
KARACHI: The event will be arranged in close coordination with American Society for Microbiology, Karachi University Microbiology Department, Bio-safety Association of Pakistan and Consortium of Scientific Societies of Pakistan.
The conference will cover almost all areas of microbiology, including genomics, proteomics and bioinformatics, molecular microbiology, Zoonotic diseases, bio-safety and bio-security for human, animal and plant health and stem cell research.
KU is going to establish an institute of Chinese language on the campus, the university’s vice chancellor has said on his return from China.
Prof Dr Muhammad Qaiser said students attending the language course would be able to attend the advanced course free of cost from the Sichuan Normal University (SNU) in China.
A spokesperson said Dr Qaiser was accompanied by KU Registrar Prof Dr Mansoor Ahmed during their visit to China.
During the visit, Qaiser signed a Memorandum of Understanding (MoU) between the KU and the SNU.
University of Karachi has started admissions in Post Graduate Diploma in Statistics and admission forms for PGD in Statistics are available in the respective department.
Sources said that the forms could be collected and accepted by December 21.
List of successful candidates for admission will be displayed on notice board on December 26. Fees will be submitted from December 27 to January 4, it was declared.
Sources further said that classes would commence from January 7, 2013.
Classes for PGD Statistics are held from 3:00pm to 5:30pm. After completion of this one year PGD in Statistics students who have completed BA/B.Sc/B.Com (Biological Sciences) becomes eligible for admission in M.A/M.Sc in Statistics and Masters in Computer Science (MCS).
The University of Karachi was established by an act of Pakistan parliament in June, 1951. The present campus, to which the University shifted in 1959, is spread over 1279 acres of land, situated 12 Km away from the city center.
Today University is recognized as a leading center of learning and research in the Subcontinent and in the Third World. A number of scientists and scholars affiliated with the University are working in important positions both within and outside Pakistan and have won gratitude and acclaim.





